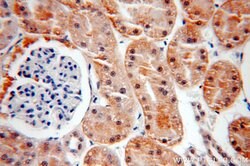
SOX13 Rabbit anti-Human, Mouse, Rat, Polyclonal, Proteintech 20 &mu;L | Buy Online | Proteintech | Fisher Scientific

missing translation for 'onlineSavingsMsg'
Learn More
Learn More
Description
This gene encodes a member of the SOX (SRY-related HMG-box) family of transcription factors involved in the regulation of embryonic development and in the determination of cell fate. The encoded protein may act as a transcriptional regulator after forming a protein complex with other proteins. It has also been determined to be a type-1 diabetes autoantigen, also known as islet cell antibody 12.
Specifications
Specifications
| Antigen | SOX13 |
| Applications | Immunoprecipitation, Western Blot, Immunofluorescence, Immunocytochemistry, Immunohistochemistry (Paraffin) |
| Classification | Polyclonal |
| Concentration | 0.37 mg/mL |
| Conjugate | Unconjugated |
| Formulation | PBS with 50% glycerol and 0.02% sodium azide; pH 7.3 |
| Gene | SOX13 |
| Gene Accession No. | Q04891, Q9UN79 |
| Gene Alias | ICA12, Islet cell antigen 12, Sox 13, SOX13, Transcription factor SOX 13 |
| Gene Symbols | Sox13 |
| Show More |
Product Title
By clicking Submit, you acknowledge that you may be contacted by Fisher Scientific in regards to the feedback you have provided in this form. We will not share your information for any other purposes. All contact information provided shall also be maintained in accordance with our Privacy Policy.
Spot an opportunity for improvement?